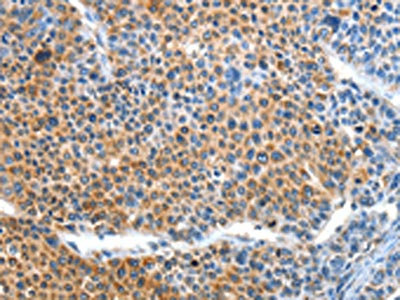

BCL2L2 Antibody
-
中文名稱:BCL2L2兔多克隆抗體
-
貨號:CSB-PA596925
-
規(guī)格:¥1100
-
圖片:
-
The image on the left is immunohistochemistry of paraffin-embedded Human gastic cancer tissue using CSB-PA596925(BCL2L2 Antibody) at dilution 1/15, on the right is treated with fusion protein. (Original magnification: ×200)
-
The image on the left is immunohistochemistry of paraffin-embedded Human liver cancer tissue using CSB-PA596925(BCL2L2 Antibody) at dilution 1/15, on the right is treated with fusion protein. (Original magnification: ×200)
-
-
其他:
產(chǎn)品詳情
-
Uniprot No.:
-
基因名:BCL2L2
-
別名:Apoptosis regulator BCL W antibody; Apoptosis regulator Bcl-W antibody; B2CL2_HUMAN antibody; BCL 2 Like 2 antibody; Bcl 2 like 2 protein antibody; Bcl 2L2 antibody; BCL W antibody; Bcl-2-like protein 2 antibody; Bcl2 L2 antibody; BCL2 like 2 antibody; BCL2 like 2 protein antibody; Bcl2-L-2 antibody; Bcl2l2 antibody; BCLW antibody; KIAA0271 antibody; PPP1R51 antibody; Protein phosphatase 1 regulatory subunit 51 antibody
-
宿主:Rabbit
-
反應(yīng)種屬:Human,Mouse
-
免疫原:Fusion protein of Human BCL2L2
-
免疫原種屬:Homo sapiens (Human)
-
標記方式:Non-conjugated
-
抗體亞型:IgG
-
純化方式:Antigen affinity purification
-
濃度:It differs from different batches. Please contact us to confirm it.
-
保存緩沖液:-20°C, pH7.4 PBS, 0.05% NaN3, 40% Glycerol
-
產(chǎn)品提供形式:Liquid
-
應(yīng)用范圍:ELISA,IHC
-
推薦稀釋比:
Application Recommended Dilution ELISA 1:1000-1:2000 IHC 1:15-1:50 -
Protocols:
-
儲存條件:Upon receipt, store at -20°C or -80°C. Avoid repeated freeze.
-
貨期:Basically, we can dispatch the products out in 1-3 working days after receiving your orders. Delivery time maybe differs from different purchasing way or location, please kindly consult your local distributors for specific delivery time.
-
用途:For Research Use Only. Not for use in diagnostic or therapeutic procedures.
相關(guān)產(chǎn)品
靶點詳情
-
功能:Promotes cell survival. Blocks dexamethasone-induced apoptosis. Mediates survival of postmitotic Sertoli cells by suppressing death-promoting activity of BAX.
-
基因功能參考文獻:
- the present study demonstrates that miR-422a may serve as a tumor suppressor in osteosarcoma via inhibiting BCL2L2 and KRAS translation both in vitro and in vivo Therefore, miR-422a could be developed as a novel therapeutic target in osteosarcoma. PMID: 29358307
- BCL2L2 knockdown was attenuated the effects of SNHG1 overexpression on cell viability, cell apoptosis and protein levels of cleaved caspase-3, cleaved caspase-9 and Bax in H2O2-treated human cardiomyocytes. PMID: 30355909
- Our comprehensive analysis indicates B-cell lymphomas commonly select for BCLW overexpression in combination with or instead of other antiapoptotic BCL2 family members. PMID: 28855351
- BCL-W contributes to the threshold of anti-apoptotic activity during mitosis PMID: 27231850
- we demonstrated that miR-126-5p plays an inhibitory role in human cervical cancer progression, regulating the apoptosis of cancer cells via directly targeting Bcl2l2. PMID: 28438233
- High expression of Bcl-w was associated with mesenchymal changes and invading populations in the glioblastoma multiforme; Bcl-w functions as a positive regulator of invasion by enhancing mesenchymal traits of glioblastoma multiforme, consequently contributing to malignancy. PMID: 23826359
- BCL2L2 was the virtual target of miR-133b, and we found a negative regulatory relationship between miR-133b and BCL2L2. MiR-133b and BCL2L2 interfered with the viability and apoptosis of cells. PMID: 27802259
- we conclude that BER treatment reduces cisplatin resistance of gastric cancer cells by modulating the miR-203/Bcl-w apoptotic axis. BER may be a novel agent to enhance chemotherapeutic responses in cisplatin-resistant gastric cancer patients PMID: 27142767
- Data show that BCL2-like 2 protein (BCL2L2) is a direct target of micrRNA miR-29b. PMID: 26155940
- these results indicate that miR-335 acts as a novel tumor suppressor to regulate ccRCC cell proliferation and invasion through downregulation of BCL-W expression. PMID: 25846734
- miR-15a acts as a tumor suppressor in NSCLC by directly targeting BCL2L2 and may serve as a potential diagnostic biomarker and therapeutic target for NSCLC. PMID: 25874488
- over-expression of miR-195 sensitized resistant cells to DOX and enhanced cell apoptosis activity, all of which can be partly rescued by BCL2L2 siRNA and cDNA expression PMID: 23526568
- Bcl-w-induced Sp1 activation is a potential marker for aggressiveness of glioblastoma multiforme. PMID: 24552705
- HDMF inhibits Bcl-w-induced neurosphere formation and the expression of glioma stem cell markers, such as Musashi, Sox-2 and c-myc. PMID: 24946210
- Crystal structure of human BCL-W in complex with different DARPins is virtually identical to the ligand-free conformation of its closest relative BCL-XL. PMID: 24747052
- MiR-335 lacks of expression brings about the abnormal accumulation of Bcl-w. PMID: 23708561
- Expression of miR-214 reduces cell survival, induces apoptosis and enhances sensitivity to cisplatin through directly inhibiting Bcl2l2 expression. PMID: 23337879
- Bcl-w protein plays a significant role in the carcinogenesis of human small intestinal adenocarcinoma. Down-regulation of Bcl-w protein in HuTu-80 cells makes them susceptible to 5-Fu. PMID: 22780970
- These findings indicate that miR-29c-mediated BCL2L2 suppression is involved in influenza virus-induced cell death in A549 cells. PMID: 22850539
- By using human cancer cells and mouse embryonic fibroblasts, the study shows that BCL-W functions in the mitochondria to increase the levels of reactive oxygen species (ROS), which subsequently stimulates the invasion-promoting signaling pathway. PMID: 22570867
- our results provide evidence that miR-335 might function as a metastasis suppressor in gastric cancer by targeting SP1 directly and indirectly through the Bcl-w-induced phosphoinositide 3-kinase-Akt-Sp1 pathway PMID: 21822301
- Data show that ABT-737, a small molecule inhibitor of Bcl-2, Bcl-X(L), and Bcl-w, significantly induced apoptosis in HTLV-1 infected T-cell lines as well as in fresh adult T-cell leukemia/lymphoma (ATLL) cells. PMID: 22138435
- miR-195 could improve the drug sensitivity at least in part by targeting Bcl-w to increase cell apoptosis in hepatocellular carcinoma cells. PMID: 21947305
- The alpha4-alpha5 hinge region is required for dimerization of BCL-W, and functioning of both pro- and antiapoptotic BCL-2 proteins. PMID: 22000515
- although the cytosolic domain of BCL-w exhibits an overall structure similar to that of BCL-xL and BCL-2, the unique organization of its C-terminal helix may modulate BCL-w interactions with pro-apoptotic binding partners PMID: 12651847
- structure of reveals a role for the C-terminal residues in modulating biological activity PMID: 12660157
- Bcl-w may play an important protective role in neurons in the Alzheimer disease brain and this aspect could be therapeutically harnessed to afford neuroprotection PMID: 15147516
- Peptide = to BH3 region of proapoptotic protein BID, bound in cleft of antiapoptotic protein BCL-w.Binding induced major conformational rearrangements in both peptide & protein components & led to displacement & unfolding of BCL-w C-terminal alpha-helix. PMID: 16475813
- overexpressed BCL2L2, through amplification or other mechanisms, promotes the growth of a non-smalll cell lung caner cell line. PMID: 17459056
- Bcl-w is a direct target of miR-122 that functions as an endogenous apoptosis regulator in these human hepatocellular carcinoma -derived cell lines. PMID: 18692484
- both uPA and MMP-2 contribute to Bcl-w-induced invasion via the stimulation of the FAK-dependent migratory pathway. PMID: 19097687
- Bcl-w is a new member of the Akt pathway PMID: 19114998
- BCL-W may function as a downstream effector of inappropriate WNT/beta-catenin signalling. PMID: 19124064
- Results show that the folate-induced DNA methylation limits proliferation and increases the sensitivity to temozolomide-induced apoptosis in glioma cells through methylation of PDGF-B, MGMT, survivin, and bcl-w genes. PMID: 19451595
- over-expression of miR-133B increased apoptosis in response to gemcitabine and reduced MCL-1 and BCL2L2 expression. PMID: 19654003
顯示更多
收起更多
-
亞細胞定位:Mitochondrion membrane; Peripheral membrane protein. Note=Loosely associated with the mitochondrial membrane in healthy cells. During apoptosis, tightly bound to the membrane.
-
蛋白家族:Bcl-2 family
-
組織特異性:Expressed (at protein level) in a wide range of tissues with highest levels in brain, spinal cord, testis, pancreas, heart, spleen and mammary glands. Moderate levels found in thymus, ovary and small intestine. Not detected in salivary gland, muscle or li
-
數(shù)據(jù)庫鏈接:
Most popular with customers
-
-
YWHAB Recombinant Monoclonal Antibody
Applications: ELISA, WB, IHC, IF, FC
Species Reactivity: Human, Mouse, Rat
-
Phospho-YAP1 (S127) Recombinant Monoclonal Antibody
Applications: ELISA, WB, IHC
Species Reactivity: Human
-
-
-
-
-